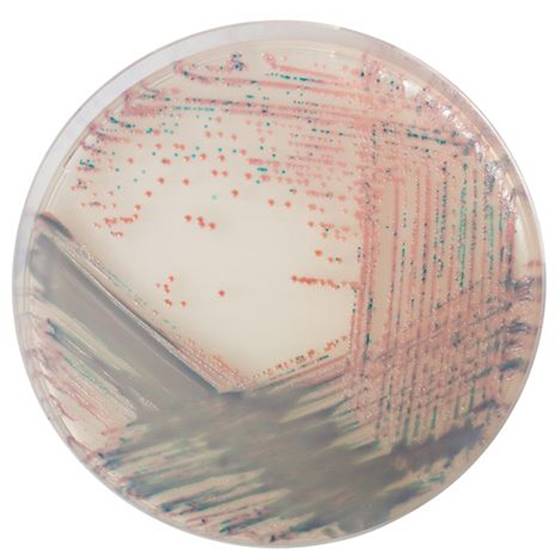

Über das Produkt
Chromogenes Medium zur Isolierung und direkten Differenzierung von Staphylococcus aureus in klinischen und industriellen Proben.
CHROMagar Staph.aureus (5L)
Chromogenes Medium zur Isolierung und direkten Differenzierung von Staphylococcus aureus in klinischen und industriellen Proben.